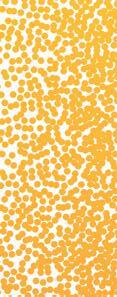
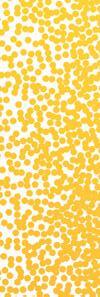

Here’s how Stamford residents are rethinking home

![]()
Here’s how Stamford residents are rethinking home

SIMPLE CHANGES THAT REFRESH YOUR SPACE
YOUR HAPPY PLACE Turn an ordinary yard into paradise with these updates
SEASONAL STYLE Easy, breezy pieces to wear now
POWER MOVES
To get an edge in business, note these trends

THIS NO-BOXES-UNDER-THE-BED MOMENT WAS BROUGHT TO YOU







52 WHAT’S NEXT FOR NESTING?
From bidding wars to rental growth, Stamford’s housing market reflects a city in transition. It’s shaped by demand that refuses to cool.
by scott thomas








Landscape pros help you rethink what’s possible just beyond your back door. Here’s how to turn the yard into an essential living space and the ultimate escape.
by tom connor


How “The Macy’s Guy” helped rally the city around care, connection and showing up.
We curate the freshest looks for spring, from casual clothing to evening outfits and accessories. Plus, A Domani sleepwear helps women keep their cool all night.
DO
Executives who want an edge in the decade to come will take these trends seriously today. And a new path to wellness begins with taking a deep breath.
Meet the Darien-based chef delivering fresh, flavorful and nutrient-packed meals to Fairfield County residents.

After years of cool grays and blues being on point, local interior designers say the pendulum is swinging, as homeowners seek more warmth and comfort at home.
by kim kavin


















The new Cohen Pediatric Emergency Center at Norwalk Hospital is the only emergency department in Fairfield County with dedicated pediatric emergency specialists from Connecticut Children’s—the only health system 100% dedicated to kids. Emergencies are scary, but they don’t have to be. Here, you’ll find marine-themed, kid-friendly spaces and expert pediatric specialists to treat everything from everyday injuries to critical emergencies.
We hope your child won’t need emergency care. But if they do, the new Cohen Pediatric Emergency Center is now open, right here in Norwalk Hospital.
Learn more









By Julie Foldesi & Stacie Morgain Lewis

















editorial director Cristin Marandino
contributing editors
Megan Gagnon–editor, athome Elizabeth Hole–editor, custom publishing
Eileen Murphy–editor, new canaan • darien • rowayton
Samantha Yanks—editor, westport • weston • wilton
copy editors
Dave Johnstone, David Podgurski
contributing writers
Liz Barron, Tom Connor, Kim Kavin, Carol Leonetti Dannhauser, Hannah Deely, Mary Kate Hogan, Jill Johnson Mann, Elizabeth Hole, Joey Macari, Jamie Marshall
art
senior art director Amber Scinto
production director Tim Carr
assistant art director Lisa Servidio senior photographer Bob Capazzo
digital
digital marketing manager Rachel MacDonald
digital assistant Lloyd Gabi
digital assistant Jeffery Garay
business president Jonathan W. Moffly
editorial director Cristin Marandino
business manager Elena V. Moffly cofounders John W. Moffly IV and Donna C. Moffly
Calendar@Moffly.com Editor@StamfordMag.com Weddings@StamfordMag.com
sales
publisher
Jonathan W. Moffly jonathan@moffly.com
sales & marketing
Gina Fusco publisher, new canaan•darien•rowayton gina.fusco@moffly.com
Gabriella Mays publisher, westport•weston•wilton gabriella.mays@moffly.com
Jonathan W. Moffly publisher, athome, greenwich, ocean house, stamford jonathan@moffly.com
Hilary Hotchkiss account executive hilary.hotchkiss@moffly.com
Morgan Howell account executive morgan.howell@moffly.com
Liz Norfleet account executive liz.norfleet@moffly.com
Kathleen Dyke partnership and big picture manager kathleen.godbold@moffly.com
Brynn John interim partnership and big picture manager brynn.john@moffly.com
Lemuel Bandala sales assistant lemuel.bandala@moffly.com
Eillenn Bandala business assistant eillenn.bandala@moffly.com TO SUBSCRIBE, renew, or change your address, please e-mail us at subscribe@stamfordmag.com, call 1-877-467-1735, or write to Stamford Magazine, 111 Corporate Drive, Big Sandy, TX 75755. U.S. subscription rates: $19.95/1 year (6 issues); $34.95/2 years (12 issues); Canada and foreign, US $40/year; $69/2 years. Prices are subject to change without notice. ALL RIGHTS RESERVED No part of this periodical may be reproduced without express permission of the publisher. ©2026 Stamford magazine is a registered trademark owned by Moffly Media. The opinions expressed by writers commissioned for articles published by Stamford magazine are not necessarily those of the magazine. FOR QUALITY CUSTOM REPRINTS/E-PRINTS, please call 203-571-1645 or e-mail reprints@mofflymedia.com 205 Main Street, Westport, CT 06880 phone: 203-222-0600 fax: 203-222-0937 mail@mofflymedia.com Publishers of GREENWICH, NEW CANAAN - DARIEN, WESTPORT, STAMFORD and athome Magazines advertising inquiries Lemuel Bandala email advertise@mofflymedia.com. published by


The mission of Breast Cancer Alliance is to improve survival rates and quality of life for those impacted by breast cancer through better prevention, early detection, treatment and cure.
To promote these goals, we invest in innovative research, breast surgical oncology fellowships, screening and diagnostics for the underserved.
To learn more scan the code

48 Maple Avenue Greenwich, CT 06830 (203) 861-0014 info@breastcanceralliance.org

Your Family. Your Business. Your Charities. Your Wealth. Your Legacy.
At Cummings & Lockwood, you receive sophisticated and carefully curated legal advice based on decades of experience and tailored to your specific goals, together with the personalized attention and elevated client experience you should expect from your professional advisors.
n Private Clients | Trusts and Estates
n Fiduciary and Probate Litigation
n Corporate and Finance
n Business Litigation
n Commercial and Residential Real Estate









































“Stand up for what you think is right—and shoot off your mouth when necessary.”
As I have now officially entered my ninth decade on earth, people have asked if I have any special secret to self-preservation. Umm. Well, here are a few suggestions, in no particular order.
Keep upbeat. Nobody likes to be around a sourpuss.
Never lose your sense of humor, as my grandmother used to say. My Jack loved taking Gammy out to lunch and having a few laughs. She was a real pip!
Don’t get sunburned. Never mind if your friends are brunettes. You’re a basic redhead and married a sailor. Lather up and cover up. Who cares if you wear your socks on the beach.
Stay curious (and brave). Don’t be afraid to try something new, even if you’re not much good at it. Mahjong? An Apple watch? Netflix? A balancing class?
Get vaccinated. Stick your arm out for anything that‘s offered (an easy walk-on at ShopRite).
Take care of yourself. The guys (usually guys) who pride themselves on never going to a doctor are often the first to drop dead of a heart attack. Why do women outlive men? In olden days, women cooked and took care of babies; men pushed the plow. Today, men sit in front of their computers, and women go to the gym.
Always have something to look forward to. Every day: A good book, a needlepoint project, a Liberty jigsaw puzzle permanently
set up in the family room. (Ok, I admit it, and a crossword puzzle book in the head.) Every week: Lunch dates with friends you need to catch up with; dinner dates and a glass of prosecco with friends you can bitch to.
It’s OK to say, “No” without feeling guilty. You’re a big girl now. Yippee!
Have Gary fix your hair every month or so. And while he’s at your house, ask him to change the burnt-out lightbulbs in the kitchen ceiling.
Have Bob Capazzo fix your neck if you look like a turtle in a photograph.
Have a tech-pro on standby. Mine’s name is Joe; but At Home in Greenwich can put you on to some good ones. Who needs the stress?
If you like what you’re doing, keep doing it. That is, as long as you’ve got your marbles. You’ll know when your time is up, or somebody will be sure to tell you.
Stand up for what you think is right—and shoot off your mouth when necessary. March for women’s rights. Go to No Kings rallies, yell and stamp your feet. Keep tuned into what’s happening politically. As a member of the Horseneck DAR, I want my patriot ancestors to be proud of me. After all, they were there for our first revolution.
Avoid people who annoy you. Life’s too short.
But Treasure your friends and relations yup, even your relations. And that’s Treasure with a capital T. After all, life is all about love, what?







How “THE MACY’S GUY” helped rally a city around care, connection and showing up | by joey macari
On a bright afternoon in downtown Stamford, car horns bounced off concrete and glass as drivers slowed and pedestrians stopped to watch. A power washer roared against the algae-stained façade of Macy’s at Stamford Town Center. At the center of the scene stood Mike Squires, phone in hand, filming what began as a personal goal and turned into a citywide moment.
“I still can’t fully wrap my head around the impact the Macy’s cleaning had,” Squires says. “It showed me how much the Stamford community genuinely cares, and how real change becomes possible when people rally together.”
The video, posted to social media last spring, struck a nerve. Squires had asked for help cleaning the green-streaked exterior that thousands of residents pass every day, and the response came quickly. Stamford Town Center and Stamford Downtown Special Services District each stepped in to cover half the cost. B3 Power Washing showed up. So did the city. As the work unfolded, the crowd reacted in real time.
“Cars were honking nonstop in support,” Squires says. “A little kid leaned out of a car window and yelled, ‘Thank you for cleaning Macy’s.’ That moment really stuck with me.”
For many Stamford residents, the video marked the first time they noticed Squires. For the city, it became something else. A shared win.
A reminder that pride in place often begins with someone willing to pick up the hose. Squires has long had an instinct to step in. He grew up in Glenbrook and moved to North Stamford after his sister was born.
“That’s really where my journey as a creator began,” he says. “I was always making something—videos of my pet reptiles, soccer clips and comedy skits with friends.”
Then, in 2011, everything changed. While attending the Academy of Information Technology and Engineering, the Squires family lost their home in a fire. “It was one of the hardest periods of our lives,” he says. “My parents are my heroes for how they handled it, and I’ll always be grateful for my community.” Stamford showed up. His school organized a bake sale. Neighbors donated clothes. One teacher, Mr. Brice, bought him a wardrobe. “Which came from Macy’s,” Squires adds.
At 15, Squires rebuilt through work, spending a summer landscaping to buy used camera gear. He started shooting music videos for friends, then for anyone who asked. “At one point, it felt like I had shot a music video for almost every artist in Stamford,” he says. Word spread and
“I want to be a part of a city we can all be proud of.”

artists from outside the city reached out. His videos garnered millions of views and travel followed. In 2016, Squires left for his first nationwide tour. Flying to Los Angeles, he cried quietly against the airplane window.
In 2017, a song he produced, “Come Home,” drew a lot of attention. “It showed me how music can connect people far beyond Stamford,” he says. Still, his hometown stayed central. “What drives me is my love for this community,” Squires says. “I want to be a part of a city we can all be proud of.”
After the Macy’s cleanup, messages poured in. Residents sent ideas, locations and frustrations. Squires listened, researched and stepped in where gaps existed, making sure to spotlight groups already doing the work. “With the citywide cleanup, my goal wasn’t just to clean,” he says. “It was to highlight those groups and amplify the work they’re already doing.”
What surprised him most came next. Kids noticed. “Visiting Rippowam Middle School for their beautification program, I was amazed by how excited and eager the students were to help their community,” he says.
His creative work continues to stretch outward. The 50 States Project,

Mike Squires of Stamford first caught the city’s attention when he rallied the community to clean the stained facade of Macy’s.

for instance, pairs Squires with an artist from every state. “You don’t have to leave where you’re from to do something on a national scale,” he says. “You can build it right where you stand.” Stamford prepared him for that scope through collaboration, follow-through and trust. The same skills he learned working locally now carry across state lines.
Today, Squires stands at a crossroads that he welcomes. “I don’t fully know what’s next, and that’s what makes it exciting,” he says. What he does know feels clear. He will keep creating. He will keep showing up. He will keep answering the questions and concerns many cities wait for someone else to handle.
“Why not me?” he asks. As Stamford learned, sometimes one person picking up a power washer can remind an entire city how much it cares.
joey macari
In a city full of ambitious teens juggling AP classes, sports practices and college applications, Stamford High School sophomore Rachel Angotto has added beekeeper and business owner to her résumé, and she’s doing it with a whole lot of buzz. Meet the founder of Honey Bunny, a local honey brand that proves you’re never too young to turn passion into something truly sweet.
The Honey Bunny story begins with a childhood lemonade stand.
“I’ve wanted to run my own small business ever since I helped my sister with her lemonade stand,” Angotto says. “Watching people enjoy something she created made me want to build something of my own.”
Since her sister had lemonade covered, and her grandfather had an abundance of honey from his hives, selling it felt like the perfect next step.
That idea eventually grew into something meaningful for the teen. Angotto’s connection to bees began with her grandfather, who started keeping hives after he was diagnosed with cancer and sought healthier, more natural foods.
“That’s what led him to learn about bees and eventually

start his own beehive,” she says. “I watched him work on it from the very beginning.” A lifelong animal lover, Angotto eagerly jumped in to help, slowly becoming what she calls his “mini business partner.”
Even the name Honey Bunny carries childhood charm.
“I grew up with bunnies in the backyard, where our first bee farm was located. So, when it came to naming the business, Honey Bunny just felt right,” she says.
She was only 6 years old at the time. What started as a hand-drawn sign for a small honey table eventually became the official logo and face of the business.
Of course, building a honey business isn’t always a smooth process. One of Honey Bunny’s biggest challenges came during the COVID-19 pandemic, when several queen bees were lost. “Without the queen, the bees stopped producing honey,” Angotto says. With demand
high, production dropped significantly. But instead of shutting down, she adapted, limiting the number of jars customers could purchase while openly explaining why honey was suddenly harder to produce. With patience, time and her grandfather’s dedicated care of the hives, production eventually returned to normal.
For Agnotto, one moment stands out above the rest.
“I received an offer to have Honey Bunny sold in a store,” she says. “It made me feel proud and excited to see how far the business had come.” Looking ahead, she hopes to expand Honey Bunny and offer it in even more retail locations. And she wants to continue growing the brand after she finishes high school and is off to college. Her goal is to grow it into a trusted local product known for its flavor and health benefits.
Stamford residents can buy Honey Bunny directly through Agnotta, as well as at Cielito Lindo Market and FreshCo in Stamford, Vima Ro & Co. in Bridgeport and Mosaico Cuisine in North Haven. One thing’s certain: Agnotto proves that when passion meets patience and a few hardworking bees, great things can happen. For more information, see @rachel_ honeybunny on Instagram

Velvety melodies, smoky rhythms, and the incomparable songs of Frank Sinatra, Tony Bennett, and Bobby Darin. Join us as a new generation of remarkable young crooners – Benny Benack III, Robbie Lee, and Shenel Johns - take on the lyrical likes of “Moon River,” “Misty,” and “I Only Have Eyes for You.”
March 19 • 8 p.m.





STAUD
Patent Ollie Bag, $250, Darien; dariensportshop.com

ASHA BY ASHLEY MCCORMICK
14k Gold Dipped Wrapped Lapis Stone, $195, Greenwich; ashabyadm.com




RAY-BAN
Wayfarer Puffer, $202, Greenwich; sunglasshut.com

STAUD
Sail Color








Blocked Polo Shirt, $295, Norwalk; bloomingdales.com



LA LIGNE Cropped Flare Trouser, $295, Greenwich; lalignenyc.com

LARROUDE
Leather Macrame
Ballet Flats, $375; larroude.com








Stretch




KERRI ROSENTHAL




















Cotton Frankie Beau-Lero Sweater, $368, Westport; kerrirosenthal.com












& EILEEN
Rory Maxi Shirt Dress, $398, Darien; dariensportshop.com

ALICE + OLIVIA









Cotton Twill Ellie Coat, $1,195, Greenwich; aliceandolivia.







VERONICA BEARD Cropped Heathcliff Lambskin Trench, $2,248.00, Greenwich; veronicabeard.com






MAX MARA Wkdbiglia Double Breasted Trench Coat, $775, Norwalk; bloomingdales.com






FRAME Suede Trench, $2,598, Greenwich; frame-store.com com






















UNSUBSCRIBED Everyday-Weight Cashmere Polka Dot Tee, $298, Greenwich; unsubscribed.com















VALENTINO GARAVANI




$595, Greenwich; saks.com






Silk Square Scarf, $640, Greenwich; saks.com


RESA Ophelia Maxi Dress, $198; shop-resa.com



Wilda Kitten Mule, $278, Greenwich; thereformation.com




REFORMATION Carolina Silk Skirt, $218, Greenwich; thereformation.com GANNI Printed Nylon Jacket, $535; ganni.com
































PETER SUCHY JEWELERS



SEAMAN SCHEPPS










Opal and Diamond Marquise Halo TwoTone Gold Cocktail Ring, $2,850, Stamford;





petersuchyjewelers.com







Lily of The Valley Pearl and 18K Yellow-Gold Earrings, $6,250, Greenwich; famillegreenwich.com



SHREVE, CRUMP & LOW






LEO PIZZO
Open-Circle Bezel Diaond Dangle Necklace, $2,795, Fairfield; hcreidjewelers.com






14K Yellow-Gold and Diamond Large Starfish Necklace, $6,600, Greenwich; shrevecrumpandlow .com










BULGARI VINTAGE
18K Gold Beaded Drop Earrings, $17,500, Greenwich; Steven Fox Jewelry, 203-302-9439











Yellow Gold with Prasiolite by David Yurman, $2,950, Stamford; nagijewelers.com





RUSS HOLLANDER
MASTER GOLDSMITH
18K Green Gold Old European Cushion Cut and Round Diamond Ring, $12,400,Stamford; 203-363-2200





Turning every day into a spotligt moment










JL ROCKS




L’ATELIER NAWBAR
Cobalt Atom Bangle, $5,5100, Westport; lbgreen.com







14K Yellow-Gold With Lab Diamond Ring, $1,650, Westport and Greenwich; jlrocks.com
MANFREDI JEWELS




14K Yellow-Gold Flexible Ring with Diamond and Clover Turquoise, $3,050, Greenwich and New Canaan; manfredijewels.com



VHERNIER

18K Rose-Gold Doppio Senso Link Bracelet, $11,900, Greenwich; betteridge.com

subtlety is overrated







TORY BURCH
Printed Silk ButtonDown Top, $695; Printed Silk Pant, $595, Greenwich; toryburch.com











TANYA TAYLOR
Crochet Tank, $345; Wide-Leg Pant, $395, Greenwich; tanyataylor.com

DOLCE & GABBANA
Silk Button-Up Shirt, $2,245, Cotton Poplin Short, $1,145; Westport; shop.mitchellstores.com


















LA DOUBLE J Silk Twill Boy Shirt, $845; Pencil Skirt, $690; ladoublej.com
ROAD G







FREE PEOPLE
Devella Cotton Linen Blend Set, $168, Westport; freepeople.com
Oversized ButtonFront Shirt and Boxer-Style Shorts, $198, Greenwich; oliveandbettes.com








FARM RIO

Sand Wonder Rio Crochet Shirt, $160; Crochet Short, $148; farmrio.com














by jill johnson mann
Everyone knows a baby can wreak havoc on a new mom’s slumber, but Greenwich resident Katya Eckert had a rude awakening (or many), when night sweats added to her exhaustion after she had her daughter in 2019. This sleep disruption is something menopausal women know well, but they aren’t the only ones battling drenched PJs.
“I had the most insane postpartum night sweats,” says Eckert. “I literally was ordering every single pair of pajamas on the market. My husband was like, ‘Our credit card bill is out of control. You should just start your own company at this point!’ ”
Eckert’s background was in finance, not garments, but she had a hunch her husband was right. She saw a market opportunity and began poking around, which meant sourcing over 650 materials. She quickly ruled out the synthetic fibers of workout wear.
“They’re made out of polymers, which are plastics that can release PFAs into your skin and disrupt your endocrine system,” Eckert explains. “That’s one thing if you’re going to a workout class and not wearing them that long. But when you’re sleeping and your body is going through all this natural cell turnover, you want something that is also going to aid your sleep and help your skin do what it needs to do, while keeping you comfortable.”

The solution: Natural “cellulosic” fiber from plants such as beechwood, birchwood, pine and eucalyptus. “Those plants are milled to a pulp, then the pulp is made into thread and the thread is made into fiber,” explains Eckert, “so all the properties of a tree, like drying quickly when it rains, are part of that fabric. It’s also naturally antibacterial, like a tree. It is moisture-wicking, breathable and quick-drying. The first time I slept in my samples, I woke up and cried tears of joy.”
It gave Eckert comfort that the A Domani line helped her mother as she battled breast cancer. “One of the largest growing customer segments I have is women going through cancer treatment,” says Eckert, “because of all of the sweating that happens with cancer diagnosis through chemotherapy and radiation, and all of the skin sensitivities that come up with it.”
In her market research, she found that some women like to sleep in dresses, others in tanks and shorts, some in short sleeves, some in long. “There aren’t a ton of sleepwear separates out there,” says Eckert. A Domani
offers them: shorts, pants, short- and long-sleeve tops, tank tops, joggers, plus short-sleeve and tank dress options—in blue, black, peach and deep red.
“The feedback has been really fantastic on the fit and the designs. We tried to reimagine the sleeper silhouette,” she says. “Sleepwear hasn’t really changed since, I don’t know … the 1970s is the current uniform, right? We had the 1950s nightgown, the chemise, and then, it went into these baggy pants and button-down collared shirt. A collared shirt is almost like wearing a scarf to bed. We wanted to design the details that would bring us comfort: All the waistbands are fold-over, so there’s no elastic that digs in. The shorts are not so short that you’re shy to walk around in front of the in-laws. The tank top seams go forward, so if you’re a side sleeper, they don’t dig in. And everything is designed for maximum airflow.”
A Domani has been featured on CBS Mornings and in Oprah Daily’s Menopause Awards. New styles, colors and a super-light fabric will be hitting the website about when this magazine lands on coffee tables. adomanisleep.com

“Unprecedented night sweats were not something I had on my postpartum bingo card. With A Domani, I said goodbye to night sweats overnight! There is truly nothing else out there that’s moisture wicking, comfortable, cute and easy to move in.”
— KERRY MCCARTHY NURSE ANESTHETIST AND MOM OF THREE

“I gifted a pair to each of my sisters and daughters. We are all ‘hot sleepers’ and are constantly on the hunt for cool comfort. A Domani is now the official BFF of hot sleepers! As a bonus, you can be cool and chic wearing the pieces around the house, to run errands and as travelwear.”
—VERNA ESPOSITO DIRECTOR OF LITTLE FRIENDS EARLY CHILDHOOD CARE AND EDUCATION
“A Domani pajamas keep me cool and help normalize my warm body temp to ensure a good and comfortable night’s sleep. I’ve washed the dress over 100 times, and it feels exactly the same as when I got it over three years ago. Invest in your rest, trust me.”
—TRACY LOCKWOOD BECKERMAN MS, RD AND AUTHOR OF “THE BETTER PERIOD FOOD SOLUTION”


Until age seven, Katya grew up in Communist Russia, where her family of four inhabited a oneroom apartment. She and her husband moved from Greenwich Village to near Greenwich Avenue in 2016. “I love being in downtown Greenwich. I just love Greenwich Avenue,” says the mom of two, Zoe and Max. “La Penguin is our handsdown favorite restaurant. It’s almost like our other kitchen. I love Richards and Veronica Beard, and Piccolina for the little kids. And obviously Tod’s Point and all of the parks and family activities.”

TEN EMERGING TRENDS REVEAL WHY THE EXECUTIVES WHO WIN NEXT WON’T BE THOSE GUESSING THE FUTURE , BUT THE ONES GETTING READY FOR IT NOW
by marian salzman
Executives love to believe they have more control over the future than they actually do. It’s a charming delusion, right up there with thinking you can outsmart Metro-North traffic on a Friday afternoon. The truth is simpler: The future arrives whether we RSVP or not. And as we march toward 2030, the leaders who thrive won’t be the ones who predict perfectly. They’ll be the ones who prepare intelligently and treat change not as a threat but as an invitation. Below are the 10 forces every executive should be thinking about and planning for, before the future finishes its sprint and lands on your doorstep. »
1. WORK BECOMES A SUBSCRIPTION, NOT A CONTRACT.
Employees used to stay in jobs because the stability felt safe. Today, they stay because meaning feels necessary. By 2030, work will function more like a subscription service than a lifetime membership. As a result, leadership must earn renewal—month to month—through flexibility, trust and clarity of purpose. Business philosophy might be less “command and control” and more “serve and sustain.”
2. AI IS YOUR SMARTEST, STRANGEST COLLEAGUE.
Executives who treat AI like a threat will be replaced by those who treat it as an amplifier. The winners in 2030 won’t just use AI; they’ll partner with it. Think of it as a hyper-competent intern who never sleeps, sometimes dazzles and occasionally hallucinates. Fluency, not fear, is the requirement.
3. PRESTIGE IS PUSHED OFF ITS PEDESTAL.
For decades, certain zip codes, job titles and alma maters served as shorthand for success. The value of those things is eroding fast. The next generation—your employees, your customers and often your children— care far less about legacy status and far more about credibility, integrity and impact. Authenticity becomes the new luxury good.
4. GLOBAL TEAMS MEET GLOBAL EXPECTATIONS.
Hybrid teams have permanently redrawn the office map. Your marketing head may be in Sao Paulo; your data lead might be in Singapore; your rising star could be in Stamford. By 2030, the most effective executives will master digital diplomacy, reading tone through screens, aligning cultures in real time and building trust across borders.
5. HEALTH SECURITY GOES MAINSTREAM.
Wellness is no longer a perk; it’s a prerequisite. We’re navigating a world shaped by pandemics, climate risks and rising anxiety. More than ever, employees will expect transparency, support and systems that protect their physical and mental well-being.
6. CLIMATE RISK REWRITES THE RULEBOOK.
Supply chains will wobble, weather will misbehave and insurance premiums will climb. As a result, environmental responsibility will shift from a PR bullet point to a business imperative. Regulators, consumers and investors will want verification, not slogans.
7. POLITICS BECOME IMPOSSIBLE TO IGNORE.
Executives used to avoid politics. That era is over. The line between business and public life has dissolved, and leaders must navigate polarization with grace and precision.
8. THE WORK CULTURE IS HUNGRY FOR PURPOSE.
We’ve already arrived at a moment of spiritual and emotional exhaustion. A few years from now, people will want to work for—and buy from— organizations that stand for something real. The future demands quiet integrity from employers that make decisions with care, show leadership rooted in empathy and embrace values that last longer than a news cycle.
9. THE ATTENTION ECONOMY CONTINUES TO SHRINK.
Eight seconds. That’s the average human attention span today. By 2030, that may shrink more. Leaders who communicate with clarity, brevity and humanity will win hearts and minds.
10. TIME BECOMES THE ULTIMATE LUXURY.
Money matters, but time—unstructured, meaningful time—will be the true status symbol of 2030. For that reason, leaders must prioritize, delegate, automate and simplify.
Marian Salzman is a Connecticut-based business executive and global trendspotter who helps companies anticipate culture, consumer and business shifts.


by liz barron
In 2019, Kirstin Mende’s parents, Maria and Hans, adopted a 10-week-old puppy named Lucky who had suffered catastrophic injuries, having been split open from chin to belly. A vet suggested the dog be put down, as it would never survive. But the family made a commitment to Lucky’s care. “Against all odds, he survived, and in doing so, showed us how many dogs are written off simply because their
cases are hard or expensive,” says Kirstin. “He inspired our mission to give dogs a real chance at life, even when the odds are against them. "
Lucky’s adoption led to others for the Mende family, and each dog connected them to rescuers in underserved regions. Those connections ultimately shaped the vision for Lucky Dog Refuge, a nonprofit cofounded by Kirstin and Maria during the pandemic. Based in Stamford, Lucky Dog re-homes roughly 150 pups a year and has found loving families for more than 1,000 pets since opening its doors.
“One thing we’re deeply proud of is we always take our dogs back if an adoption doesn’t work out," says Kirstin. "Returns do not happen that often, but still, we will always be a safety net for our dogs."
The organization is distinctive for its efforts HOW A PET NAMED LUCKY INSPIRED A STAMFORD-BASED RESCUE SANCTUARY DEDICATED TO THE RE-HOMING OF THE MOST VULNERABLE DOGS




to help dogs with complex medical needs.
“We take on dogs that require heartworm treatment, orthopedic care and amputations, emergency and lifesaving surgeries, and intensive treatment for severe mange and neglect. We also specialize in helping vulnerable pregnant and whelping mothers, neonatal puppies, and dogs battling parvovirus and other critical illnesses,” says Kirstin. “These are the dogs most often at risk of being euthanized simply because they need more than basic care. Our mission is to give them the time, the treatment and the chance they deserve to heal and thrive,” she adds.
Medical cases can be very expensive. According to the Lucky Dog Refuge website, the organization spends an average of $2,500 per animal. Donations, grants, partnerships and sponsors are crucial to its ability to cover the medical costs.
A legacy fund was recently created in memory of Chris Collins—a dedicated volunteer for Lucky Dog Refuge who died in 2025. It helps ensure that dogs aren’t turned away because of costly medical needs. “It’s a promise that every life is worth saving,” says Kirstin. “And the fund serves as a lasting tribute to Chris’s kindness.”
Lucky Dog shelters up to 38 dogs at a time and strives to give each animal the attention and care it needs. Dogs are treated to multiple walks per day and given opportunities to socialize, thanks to the efforts of volunteers and staff members. There are eight to ten staffers on-site per shift.
“I grew up with dogs—lots of them. We always had at least five, and for a long time I thought that was completely normal,” says Chantal Erensen, a volunteer. “My mom rescued dogs from the street, the pound, wherever she could. Today, I have four rescue
dogs of my own.” Erensen’s interest in rescue dogs began about 15 years ago, when she began to recognize the difference between rescuing a dog and buying one from a breeder or store. “I became aware of the implications for mother dogs, the animals that never get sold, and the widespread issues of neglect and abandonment. The reality is heartbreaking.”
The adoption process is open to applicants who are 25 or older. They can apply through the organization’s website. Applicants are asked to provide home photos, references and veterinary history. A meet-and-greet for the applicant and dog follows. Once a solid match has been made, contracts are signed, fees are paid, and the dogs are sent home with their forever families.
“But adoption is not the end of the relationship,” says Kirstin, who lives in Darien. “We support our adopters for the life of the dog, through alumni events, pack walks and even boarding, so our dogs always have a safe place to land.”
Kirstin says many aspects of her work at Lucky Dog Refuge are rewarding, but one of the most satisfying things to observe is the transformation. “Seeing a dog arrive frightened, injured or shut down, and then slowly realize it is safe and loved. That's incredibly powerful.”
The Lucky Dog Refuge facility at 36 Pulaski Street was built to look and feel like a regular home, and there’s a large play space on the lower level that’s along the Mill River, where dogs can run, play and get fresh air. There are dedicated places for nursing puppies, quarantined dogs and new rescues. "The facility is a true refuge," says Kirstin, where dogs are given compassion, medical care, training, emotional safety and the second chance they all deserve.

AT SOVEREIGN GALLERY, A NEW AND UNEXPECTED STUDIO IN GREENWICH, MANNY VALERIO AND HIS TEAM TURN PERSONAL HISTORY INTO FINE ART
by beth cooney fitzpatrick
The way Manny Valerio sees his art, the best tattoos illustrate a personal story.
“I think they should be mementoes of your life,” Valerio says. “They should say something meaningful about who you are and align with your experiences and values.”
The ink on Valerio’s body reflects the same thoughtful, artistic approach he takes when creating the finely detailed inkwork he offers clients at the Sovereign Gallery, his six-yearold East Putnam Avenue tattoo studio and art gallery.



Thursday, April 16 from 6 to 8:30 p.m.
Join us for an evening of food and festivities to benefit the Ferguson Library at the Main Library, DiMattia Building, Bedford and Broad Streets, Stamford.

Honoring Susan and Edward Greenberg for their service to the library and the Stamford community.
Tickets are $200/sponsorships available. Reserve at fergusonlibrary.org or call 203 351-8251.
Lockwood, LLC
Anne Downey and Ken Wiegand
Fiduciary Trust International
Irish-American Cultural Society
Randie Katz and Larry Cryer
King School
Rich Foundation Ann Sexton
Beverly and David Stein
Swerdlick
Temple Beth El
Dilenschneider Group USI Consulting Group
ALVAREZ Jane Brooks
Susan and Paul Duarte Family Centers First Bank of Greenwich
Sam and Emily Gordon
Grosso Hofmann and Richard Hofmann
Belle Horwitz and Jon Weiner
Margaret and Albert Lardizabal
Joseph and Linda Milano
Lindsey Miller and Susan Sawyer Arthur and Betsey Selkowitz
Susan Toliver and Stephen Perry
IN-KIND SPONSOR
MBA Graphics
MEDIA PARTNERS
Hey Stamford
Stamford Magazine/Moffly Media–Exclusive Magazine Sponsor
The Ferguson Award created by Russ Hollander, Master Goldsmith
March 28th from 2pm-5pm

www.spedlegalfund.org



Take his first tattoo—rap lyrics he had etched onto his torso while a 16-year-old student at Stamford’s Westhill High School.

“ we have clients in town who are ceos and celebrities and professional athletes. we have people who fly in to get work here. the other day, we had a sneaker designer, a botanist and a zoologist, all getting tattoos at the same time.”
– manny valerio
“To be honest, it’s probably not the best tattoo,” he laughs, noting there’s even an embarrassing typo in the lyrics. “But it’s important to me, and I still love it, because it reflects a place and a time that was so much a part of me. It reminds me of being a kid, hanging with my friends, playing basketball and having fun.”
He embraces the same nostalgia for the tattoo of an avocado he sports on an ankle. It honors a beloved Dominican grandmother, who lived until 109 and always served fresh avocado slices alongside simple meals of rice and beans during his family’s visits to her mountainside island village.
More prominent in Valerio’s personal ink gallery are the words “Ambition” and “Grateful,” tattooed like rings on his fingers.


If the answer is yes, the team at Sovereign Gallery offers these tips for anyone considering body ink.
• Have a Plan
The gallery team offers consultations, which Valerio recommends to anyone considering tattoos.
• Get a Quote
Tattoo work can be nuanced and complex. Some small designs can be more intricate than larger ones, so understand that tattoo art is often billed based on the hours it takes to complete a design rather than its overall dimensions.
• Cultivate Your Style
Much like painters, tattoo artists often have distinct approaches to their inkwork, each yielding different aesthetic results.
Consider whether you want something delicate, bold, black and gray or colorful. “Do your research, and know what you like,” says Valerio.
• Start Small
For anyone squeamish or worried about a tattoo’s permanence, some diminutive starter art is the way to go. Avoid a first tattoo on frequently exposed areas such
as the neck, hands, wrist, arms, shins and ankles.
• Prepare for the Ouch
“I tell people if they tell themselves, 'It’s going to hurt a little bit but I’ve got this,' they’ll do well," says Valerio. “We work really hard here to make the experience as comfortable as possible, and I think most people find it tolerable. We play good music, have good conversation. We have had people laying on the table for hours without a complaint.”
• Avoid Mixing Ink and Romance
Case in point: The gallery client who got a tattoo of her boyfriend’s name a scant month before their unexpected breakup.
“I see tattooing the name of a significant other on your body as a kiss of death,” says Valerio. “You can get rid of tattoos, but the process isn’t easy.”
• Check Spelling and Facts
Valerios’s first tattoo contained a typo. The word “fulfill” was erroneously spelled “fullfill.”
So he stresses the importance of the not-so-small details.
“I know people who have gotten important dates and people’s names wrong.”
The conspicuous hand art speaks to his equally bold (and risky) decision to open a tattoo studio along a retail landscape largely populated by luxe home design studios and clothing boutiques.
“Greenwich might not seem like the kind of place that would welcome or support a tattoo business, and we had landlords on Greenwich Avenue say, ‘You can come here, but you can’t put the word tattoo in the window,’ Valerio says. “I believed if I could bring a high level of artistry to the business and the right aesthetic and vibe, we could succeed. And we have exceeded our expectations. Indeed, the award-winning tattoo artist, who has trained with some of the best tattooists in the country and developed his own international fan base, believes the gallery is thriving for reasons ranging from a generational shift in body art acceptance to his entrepreneurial instincts and a diverse team known for their high-level artistry. “We like to think we’re a good surprise that makes Greenwich a little more interesting.
“We pride ourselves in being Greenwich’s premier tattoo studio, but we’ve become more,” Valerio explains. “We are an art gallery that also exhibits the work of other artists, which says something about how seriously we take what we do. One of the reasons why I love working here is because what we do is so unexpected and elevated. We have clients in town who are CEOs and celebrities and professional athletes. We have people who fly in to get work here. The other day, we had a sneaker designer, a botanist and a zoologist all getting tattoos at the same time.”
“But I think the thing that everyone we work with has in common is that they value what they put on their body,” he says.
Valerio’s path to the Sovereign Gallery was a circuitous one. He emigrated from the Dominican Republic as a toddler with his parents, the family settling on Stamford’s West Side, close to the Westover Elementary School,
which he eventually attended. Early struggles learning English, helped cultivate his creative side. “My teachers would say, ‘He’s quiet, but always drawing.’ I think I couldn’t communicate well, but was good at observing.”
Inspired by his parents’ immigrant ambitions, tireless work ethic and success, he shelved early dreams of art school and a career as an illustrator or graphic designer for seemingly more pragmatic plans to study engineering at the University of Connecticut.
Then came a creative detour: Valerio bought an RV and spent 18 months touring national parks and the studios of the talented tattoo artists he admired in each of the 48 contiguous states he visited, taking time to do hands-on work in each.
“They all had different styles, but I learned something from each and every one of them,” he says of the adventure that kept him on the road until 2018. “And by the time I was done, I had my own style. And I even had a following.”
That following led him to launch Sovereign Gallery, where he now works alongside fellow artists Thomas Bork and Marcos Silvera, as well as frequently rotating the roster of guest artists who come from far-flung places to see local clients. Each team member works in a distinct style, drawing on versatile talents that meld traditional and innovative approaches to tattoo design. Silvera is known for his strong work in color. Bork excels at delicate imagery, including botanical illustrations and geometric designs. Valerio’s clients seek him out for his precision work in black and gray realism as well as his exceptional abilities in portraiture.
“I think we’ve all developed our strengths by doing what comes most naturally to us,” Valerio says. “And that gives our clients a lot of options in terms of developing their own aesthetic. They come here knowing they are leaving with more than a tattoo. The quality and the intention put into the art matters to them.”

by georgette yacoub

Jenn Warwick spent most of her life in motion. A college athlete and longtime fitness instructor, she lived by discipline, drive and performance. On the outside, she appeared to be thriving. But inside, a quiet heaviness lingered—an unshakable weight that followed her from adolescence into adulthood.

“I didn’t even realize or could identify that I was struggling with depression,” she recalls. “But it’s been a thread in my life since my early teens.” Perfectionism, relentless standards, a persistent inner critic— these were familiar companions. And even after leaving a career in finance, the feeling persisted. It wasn’t until she became a mother that everything changed. “There wasn’t a specific trauma, but I knew I wasn’t really living. It wasn’t sustainable.”


That was the turning point. Motherhood surfaced the emotional toll she had long suppressed. She left her highpressure job in finance and pivoted into the fitness and wellness world—a space that felt more aligned with her values but still didn’t fully address what was going on beneath the surface.
“That relief was good, but not enough,” she says. “I was still hypervigilant about the perfectionism. I felt like I was just spinning.”
Then she found breathwork. Warwick was introduced to transformational breathwork through trainers she worked with. She dove into journey work—a deeply immersive style of breathwork that spans more than an hour, designed to access the subconscious mind. “It’s not like you just take a class and feel better,” she says. “It was the first time I felt any kind of real relief. Talk therapy didn’t touch it because I was masterminding my own story.

“when you’re doing transformational breathwork, you shift into a different brainwave state.”
– jenn warwick, founder of breathe for life
But when I breathed, my body could finally speak.”
That distinction is key. While meditation asks us to quiet the mind, breathwork invites us to move through it—to physically alter our internal state through breath alone. “When you’re doing transformational breathwork, you shift into a different brainwave state,” Warwick explains. “You move into theta, a state of deep relaxation. That’s when the subconscious opens and the protective mind quiets down.”
Sessions are structured like a journey. Clients lie on yoga mats, wearing eye masks and headsets with healing soundscapes playing. Warwick guides them through conscious connected breathing—a circular breath technique through the mouth for roughly 45 minutes. Sound healing frequencies and binaural beats run through the headphones, creating a full-body immersive experience.
“There’s an arc to every session,” she explains. “We begin quietly, then activate the body. At certain points, people may audibly sigh, cry or even scream. It’s all about giving the body permission to release what’s been stuck.”
In her eight-session program, The Breath Shift, clients often experience powerful transformations. Some connect with long-lost parts of themselves. Others release stored emotional pain. “I’ve had people come out of a journey and feel like they let go of anger they’ve carried for decades,” she says. “They finally feel light.”
For those not quite ready to commit to a full journey, Warwick recommends starting with simple, daily breathwork to support nervous system regulation. “Three times a day, just take five slow breaths through your nose,” she advises. “Box breathing is great, too— inhale for four; hold for four; exhale for four; hold for four. It’s about giving your body a chance to reset.”

Even just nose breathing has an impact. “When you breathe through your nose, you signal safety to
“it’s all about giving the body permission to release what’s been stuck.”
– jenn warwick says of breathwork
the body. It slows you down. Your nervous system reads that and shifts into a calm state.”
Ultimately, breathwork gave Warwick something she never found in all her years of movement and achievement: access to her own inner knowing. “It’s a nervous system regulation process,” she says. “And when you have that agency in your body, you can return to yourself. You can ask, ‘How do I feel? What’s off?’ And trust what comes up.”
Warwick offers private sessions, group classes, and her eightsession journey program in Darien and surrounding towns. She also has a new space opening in Old Greenwich at 26 West End Avenue, where she’ll be hosting small-group sessions. These one-off classes are designed for anyone curious to explore breathwork in a welcoming environment. Sessions are open to all, and you can learn more by visiting breatheforlife.net or following her on Instagram @breatheforlife

Meet the DARIEN-BASED CHEF DELIVERING FRESH, FLAVORFUL AND NUTRIENTPACKED MEALS to Fairfield County residents



Chef Lisa Clarke’s love of fresh food began in her childhood in 1980s Ireland. “My mom was a fabulous chef and very ahead of her time,” Clarke recalls. “She always used fresh produce, most of which was grown in our own garden.” For Clarke, a diet rich in fresh, homegrown ingredients has always been second nature.
Driven by her passion for food and entrepreneurship, Clarke’s career evolved from an afternoon tea business to founding a catering company that helped hosts and hostesses create memorable and mouthwatering dinner parties. Then she really found her groove: a meal delivery service.
During the pandemic, Clarke’s close friend Dr. Katie Takayasu—a well-known integrative medicine physician and owner of Wellness Insights in Darien—was in the early stages of developing a detox meal plan for her patients. The two women decided to collaborate. “We realized how much people were craving comforting nutrition without the added stress
of cooking every night,” says Clarke.
While Clarke honed her culinary skills in her mother’s kitchen and numerous culinary classes over the years, she says she’s learned a lot about health from Dr. Katie. “I have benefited so much from her experience, wisdom and expertise. Her approach to health considers the patient as a whole, and she digs so deeply into finding out how she can make people
feel better,” says Clarke. “She’s an incredible resource to have in our community.”
This fall, Dr. Katie officially handed the reins of the meal program to Clarke and Nourish by Chef Lisa was born—continuing the shared mission of “inspiring people to live and eat well,” says Clarke.
Her five-day programs feature organic, glutenand dairy-free meals, always with vegetarian options available. Focused on balanced nutrition, each day’s menu provides around 90 grams of protein, at least 30 grams of fiber and a bounty of plant-forward dishes. The menus evolve with the seasons, highlighting the freshest ingredients.
“My inspiration draws from a little bit of everything—cuisines from different countries and many wonderful meals that I’ve had during my travels,” says Clarke, who believes food should always taste amazing and never compromise on flavor. “I want my clients to feel energized, fulfilled, balanced and happy through simple, nourishing meals.”





“my inspiration draws from a little bit of everything, cuisines from different countries and many wonderful meals that i’ve had during my travels.”
– chef lisa clarke
Clarke’s culinary creations come to life in a bright, spacious, fully equipped commercial kitchen in Darien. Her menus change weekly and include three perfectly balanced meals and a daily snack.
Her creativity in the kitchen is fueled by the joy of introducing clients to new foods, tastes and ideas. She loves giving familiar dishes a fresh twist and says she often receives feedback from clients thanking her for using ingredients they had never tried before.
She values client feedback, especially when
it comes to deliveries. “Ensuring that every meal arrives fresh and delivered in a visually appealing way can definitely be a challenge,” says Clarke. “As a team, we’ve really taken feedback into consideration and refined the way we do things. Hard work and paying attention to detail pay off.”
Curating meals for her husband Bernard and their four children, Clarke admits, can be a bit more challenging. “It’s definitely convenient to serve them the same menu that I’m cooking for the program, but my kids aren’t
always excited to eat dishes like plant-based meatballs,” she jokes. However, she is happy her kids are being exposed to different types of cuisine at a young age.
The biggest reward for Clarke, whether it’s cooking for her family at home or her clients through Nourish, is knowing the meals she is preparing are helping them to live their best, healthiest lives.
Nourish by Chef Lisa meals can be delivered to residences in lower Fairfield County. Visit nourishbycheflisa.com or follow on Instagram @nourishbycheflisa to learn more.






AUX DÉLICES CELEBRATES 30 YEARS AS FAIRFIELD COUNTY’S FAVORITE DESTINATION FOR EASY, ELEGANT MEALS
by mary kate hogan • photography by venera alexandrova
Translated from French, délices mean “delight” or “delicious,” and aux délices is said to express “what a treat!” The café and catering business of the same name has been treating our towns for decades now. Celebrating its 30-year anniversary last December, Aux Délices epitomizes the term “everyday gourmet,” having grown over the years
to four locations (Riverside, Greenwich, Darien and Westport) as well as The Café at the Bruce Museum. Aux Délices has thrived by evolving over time while retaining its classic appeal and by simply providing top-quality, home-cooked dishes. Not many places can claim to be simultaneously people’s go-to spot for coffee (or that addictive ginger tea) and healthy meals on the
go, while also being the caterer that launched a thousand holiday feasts and weddings. Aux Délices has filled that spot for us, serving up stylish food that may be the best culinary shortcut around.
How do they stay so popular?
“We’re always trying to improve things, whether it’s just the food or looking for ways to
innovate,” says Debra Ponzek, who co-founded the company with her husband Greg Addonizio. Both are graduates of the Culinary Institute of America. When they first opened the shop in Riverside, it was an opportunity for the couple to work together in a food business that’s more conducive to raising a family than working as top chef at a Manhattan restaurant.
With roots in French cuisine, Debra was the executive chef at Montrachet in New York, where she received the James Beard Rising Star Award in 1992 before leaving to start Aux Délices. Her French culinary expertise was showcased in the early days of Aux Délices, but soon, “we molded our menu around what our customers wanted,” Debra says. “You have to get out of just cooking for yourself. Coming in as a chef—we always laugh about this—we had in the cases on a Tuesday rack of lamb, pheasant and sea urchin! I love cooking, and it was a learning curve.” In short order, the menu shifted to more family-friendly meals, cooked to the highest standards and fulfilling the wishes of customers. People would come in requesting a certain soup or a particular rice dish, and Debra obliged.
At the time, Debra was content cooking for the Riverside community, while Greg focused on growing the business. During the early months, she was pregnant with their daughter, and later they kept a pack-and-play upstairs at the café. They became experts at balancing work and family life. Moving from Easton, they raised their three children in town so they could be close to the shops while also able to pop out to attend one of the kids’ school plays or activities.
“We were able to be home at a reasonable time, and it was feasible to have a meal with our kids,” she says. The kids would go on to become taste testers for her cookbooks and also logged hours working the cash register and helping




“ we’re lucky to have customers that have been here since we opened, who are older now, and their kids, who come in from school.”
—debra ponzek
to make boxes for the holiday meals. Kids' cooking classes became part of the lineup, too.
The couple’s children aren’t the only ones who grew up with the business; the customers span the decades, too. “We’re lucky that we have customers that have been here since we opened, who are older now, and their kids who come in from school,” she says. Along with the
multigenerational customer base, Aux Délices has a loyal staff. Among the friendly, knowledgeable team, there are some who have been onboard for 20 years.
As Aux Délices expanded, the couple intentionally kept the radius within Fairfield County, because they like to be present in person. “We are on-site every day in the stores, looking at things, noticing things we love, going through the store. It was important for the stores to be within driving range. We’re kind of control freaks,” she says with a laugh. “Always wanting to know what's going on.” This was true as they opened Darien and Westport and updated the menus.





as aux délices expanded, the couple intentionally kept the radius within fairfield county because they like to be present in person.
Customers line up every day to pick up a salad sampler (try Gloria’s chicken, shrimp salad and shaved Brussels sprouts, among many others) or a sandwich for lunch. The orzo and arugula salads have a cult following—the perfect sides for a picnic, or a lunch or dinner at home.
There are shaker salads, bento boxes and packaged salads as well as grab-and-go dinners ranging from turkey chili and chicken enchiladas to beef bourguignon and chicken pot pie, along with delicious cakes for celebrations. Everything is made from scratch, including the mayonnaise used in salads and sandwiches, and the broth for soups (there’s also bone broth available to-go by the cup), making it all taste that much more delicious.
The team works on keeping the surroundings as fresh as the food. This year, they are doing a redesign at all stores, tweaking color palettes and modernizing certain details to keep the spaces appealing to all ages. In Riverside, they’re adding a new coffee bar as part of the update.
Although holidays are the busiest times of year at each location, many families turn to
Aux Délices to provide their meals on a yearround basis. The menus change slightly but you can count on classics like Debra’s family recipe for brioche-sausage stuffing and a much-loved brisket. “I feel like it’s a big responsibility to prepare people’s meals,” she says. “It’s a lot of fun, but we take it very seriously. It means a lot to us that people trust us to put our food on their tables.” All holiday meals are delivered for free, but Aux Délices delivers throughout the year, a service that started during the pandemic.
Debra and her team are also focused on giving back. She is on the board of the Undies Project and also works with Kids in Crisis and Covenant House, among others. As part of the 30-year anniversary celebration, the team will be donating a portion of proceeds to charitable organizations. They will also host special events and deals to thank the community.
“We’ve been supported by the community for all these years, and we don’t take that for granted,” Debra says. “It’s amazing to me that we’re here and that Greg and I still love doing what we do.” auxdelicesfoods.com




















































March heralds spring cleaning: time to assess, organize, clean and purge areas you might have overlooked during the year. P.S. Remember to include your financial adviser in that assessment.
As the seasons change and the years pass, your financial needs and goals change, too. Your financial gameplan should be adjusting as well, with investments and strategies tailored by a person who understands your unique
situation, says Hillary McGrail, senior relationship manager at King Financial Network in New Canaan.
“There can be 100 people in a room, and each person has had their own individual experience with finances, money and financial matters. It’s very personal,” McGrail says. The adviser’s job, she notes, is “making sure we understand everything that’s important to you in your financial life.”
When that’s not happening, it could be time to cut the cord.
How can you tell if your adviser is lacking? Look for the red flags, she says. McGrail spent the early part of her career guiding institutional investments and advisers nationwide before migrating to the client side. The switch proved eye-opening.
Prior to moving to King, she witnessed so-called advisers talking down to their customers or ignoring one partner over the other, only to backpedal when an unexpected money event, such as a big tax bill, arose.
“Red Flag No. 1: lack of communication and attention,” says McGrail. Good advisers reach out at least quarterly, even if that’s just with an email or a phone call to touch base. During meetings, your adviser should be “doing a lot less talking than you. You should be conveying what’s important to you, what’s new with you.” If your expert is doing more talking than listening, McGrail says, maybe it’s time to move on.
Red Flag No. 2: leading with a product instead of a query. When you buy something from your advisor and they make money, that’s transactional, not personal, and “it’s still the way many advisers are trained,” McGrail laments.
That leads her to Red Flag No. 3: lack of transparency and clarity on what you own and what your fees pay for. If you don’t know, it’s time to ask. Be upfront with your questions, McGrail recommends. Say “I don’t know what I’m paying for. What is the cost to me? How are you compensated? How does
your fee structure work? Where are my assets held?”
Your adviser should be forthcoming with these answers and have a team of experts— CPAs, estate attorneys and more—at the ready to help provide a holistic approach. At the end of the day, you—and they—should understand your risks and market exposure, your cash flow needs and upcoming goals and your plan for reaching those goals.
Breakups don’t happen fast. Steps leading to a split might include high fees, bad customer service, lagging portfolio performance or simply your money manager’s complacency, especially when the market performs well and gains seem to come on autopilot. The average age of a financial adviser is 51, according to Integrated Financial Group. If your adviser is on the golf course instead of talking you through the financial challenges keeping you up at night, McGrail says, wave your own flag goodbye.
Before you cut the cord with your current adviser, consider your next move: will you do it yourself or go with a robo plan? Or enlist the services of a money manager who actually serves you? Ask people you know and trust for recommendations. Do your homework and arrange some interviews. In your meetings, is the potential adviser really listening to you and asking about your fears, hopes and dreams? If not, keep moving.
Once you find someone new, that person can transfer your investments and take care of the paperwork, without you ever having to say goodbye to adviser No. 1. “If it’s someone close in your network or community, you can be gracious and say, ‘Thank you. You’ve helped us so much,’” McGrail says.’” But you don’t have to.









SATURDAY,

THURSDAY,




HONOREES
Humanitarian Award
Giovanna Miller
Corporate Leadership Award
Crabtree Motor Group and the Crabtree Family
Exceptional Service Award
Admiral Lisa M. Franchetti, United States Navy (Retired)
To purchase tickets, sponsorships and journal acknowledgments, please scan the QR Code or visit redcross.org/mnynball.















Moffly Media is one of the leading providers of professional event photography and marketing services in Fairfield County. We capture compelling, high-quality images of individuals and groups at meaningful events. With our wide range of capabilities from video to social media, Moffly will customize a marketing program that’s just right for you.





BY ANDREA CARSON






Filling in the Blanks


ocals teamed up to help fight childhood hunger at the fifth annual Influencer Packing Event. The volunteers packed food for children in need who receive weekend meal bags from Filling in the Blanks. fillingintheblanks.org »
Em Roberts, Julia Dzafic, Stefanie Jones, Megan Schinella, Marika Dominczyk, Julie Stewart Middle row: Pam Alberino, Kira Jones, Emma Rojas, Nina Clarke, Doreen Godfrey, Lauren Sklover, Jessica Ryan Gina Demeo, Kelsi Nyman, Raenah Farina, Michaela Visconti, Stephanie Webster, Ashley Langer, Zac Mathias, Amanda Gershman, Julia Dzafic 3 Sam Ball 4 Julie Stewart, Nina Clarke, Emma Crojas, Zac Mathias 5 Megan Schinella, Amanda Gershman, Danielle Kilarjian, Doreen Godfrey, Ashley Langer 6 Em Roberts, Gina Kelsi Nyman, Raenah Farina 8 Filling in the Blanks
Founders Shawnee Knight and Tina Kramer with actor Marika Domińczyk













ith the help of famed UConn women’s basketball coach Geno Auriemma, golf enthusiasts teed up support for Connecticut Children’s Foundation. His annual charity golf tournament, Geno for The Kids, took place at Norwalk’s Shorehaven Country Club, where golfers competed in exciting contests throughout the day. Following a competitive outing on the course, guests attended a cocktail reception and dinner. Proceeds benefit Connecticut Children’s efforts to ensure “every child facing health challenges receives the expert care they deserve, close to home.” connecticutchildrensfoundation.org





Thursday, April 23, 2026 6:00-10:00PM
The Loading Dock



Be a part of changing lives. Support homeless prevention, crisis services, and paths to housing stability.

Learn more about tickets & sponsorships





















Go ahead, try it out. Point your phone’s camera at the Flowcode to scan.
by








Jennifer was just beginning her doctor of physical therapy program at Sacred Heart University as Andres was completing his master’s in healthcare administration at George Washington University. She needed to become CPR-certified. Her brother, who volunteered alongside Andres at the Cos Cob Fire Police Patrol, knew Andres taught CPR for Greenwich EMS and introduced them. The pair arranged a private CPR class at the Cos Cob Firehouse—and, well, sparks flew.
Jennifer and Andres moved in together at the start of the pandemic and found joy in simple routines like bringing breakfast on a Saturday to the Belle Haven Club to enjoy the peaceful views along the water. The club was special to them, as Andres grew up there. So he knew BHC was the perfect spot to propose.
One evening, Andres led Jennifer up to the top deck overlooking the water, where flowers and floating candles were waiting. As he got down on one knee, their families and closest friends were secretly gathered downstairs, sneaking peeks and holding back their excitement as they watched the proposal unfold.
Rev. Michael K. Jones officiated at the ceremony at Saint Mary Church, and the reception followed at Innis Arden Golf Club. In one of many touching moments, Jennifer shared a dance with her grandfather, Joe, to one of his favorite Italian songs.
The bride, daughter of Benjamin and Patricia Freda of Greenwich, graduated from Greenwich High School and Sacred Heart University. Jennifer is a physical therapist at Stamford Hospital.
The groom, son of Manuel and Silvia Moreira of Greenwich, graduated from Greenwich High School, Syracuse University and George Washington University. Andres is a hospital administrator for Mount Sinai Health System in New York.
The newlyweds honeymooned in Newport, before returning home to Greenwich.

From bidding wars to rental growth, Stamford’s housing market reflects a city in transition, shaped by demand that refuses to cool by scott thomas

Over the past two decades, Stamford has seen nearly everything in its real estate market, including downturns, upward movement, a long-running steady transactional equilibrium, a post-Covid demand surge and a swift increase in population. The city is now the second largest in the state, with nearly 18,000 new residents in the past 15 years
The past year saw the continuation of a trend that has defined the real estate landscape: Inventory has been tight, as residents with low interest rates on homes they purchased or refinanced years ago have found financial contentment and hesitate to sell. When a single-family home does hit the market, buyers move swiftly, frequently resulting in multiple offers for the seller.
In addition, more apartments have hit the Stamford market in the past few years. As a result, some people have discovered the dream of home ownership is not so high on their priority list. It all adds up to a complicated, large-scale real estate jigsaw puzzle that continues to evolve. These trends, and others, are shaping Stamford’s residential property landscape for the next generation.
Demand for housing in Stamford remains unusually strong. The city’s population grew by 10 percent from 2010 to 2020 and surged to more than 140,000 residents in 2024. According to the city’s master plan, the population is expected to rise to 152,000 by 2035.
The increased demand for housing has created an
inventory bottleneck. Homes that come to market are snapped up quickly, and sellers often see multiple offers. Buyers need to move lickety-split, but even then, there is no guarantee their offers will be accepted. Some sellers prefer cash offers; others are unwilling to negotiate on contingencies. This unusual dynamic has been in place for the past few years and is likely to continue.
“Demand remains very high against very low supply,’’ says Barbara Hickey of William Pitt. “Nothing has changed in that regard. Sellers are in the driver’s seat, provided they don’t reach for the stars.”
Inventory in Stamford declined by 15 percent through the third quarter of 2025 compared to 2024, according to
“If interest rates get a little better, then I think inventory will continue to improve. It won’t become a buyer’s market, but it will be a better market. It’s a move forward, and eventually we will return to a more balanced market for buyers and sellers.”


a market report by William Pitt. And the median selling price increased by 8 percent to $871,000, the report said. At the same time, buyers have become more astute, according to Staci Zampa of Compass. “There are fewer buyers for each house, but the those who are out there are much savvier,’’ she says. “They know the market; they’ve done their homework, and they’re making smart, thoughtful decisions. The segment between $850,000 to $1.2 million is still incredibly active. That part of the market has been just crazy.”
While many people still covet single-family homes, the scarcity of land has prevented developers from building houses. The result is more rental units, with more on the short-term horizon. In December 2025, for instance, the Stamford Zoning Board discussed a proposal for 261 units (201 apartments, 60 townhouses) on nine acres at the former site of Conair. Neighbors in the Waterside area have expressed concern about the number of rentals to be built.
“There has been a trend toward more rental units for
“I tell younger buyers to put themselves on a budget. Start
by cutting all the frivolous things. Drive an older car; don’t trade in the old car because you want a lease. Say no to the overseas trip. If you sacrifice upfront and you’re conscientious, little by little, it adds up so quickly. It takes work, but it can be done.”
years, and I don’t believe it’s a great thing,’’ Zampa says. “Developers and the city make more money building rentals than condos. At the same time, there’s not a lot of land left for single-family homes, and what’s available is usually used for senior living or more rental projects.”
The demand for more rental units is a nationwide trend. A Census Bureau report found that almost 592,000 apartments were finished in 2024, a 50-year high. The growth represents a trend among younger residents, who prefer the flexibility and lower financial commitment of renting. This demographic also shows a preference for urban living, which usually presents more job opportunities and convenience.
“We don’t have a lot of land left,’’ Hickey says. “The Stamford Land Conservation Trust works hard to preserve the chunks of land that are out there. And the homes that are out there, they’re not for the modest wage earner. With rental properties, we’re at 95 percent occupancy. There’s essentially no vacancy. History just keeps repeating itself. But at some point, there will be a glut of rentals, and a developer will convert them.”
Stamford’s real estate market has remained gridlocked for the past few years, due to a lack of inventory. Many real estate professionals thought a dip in interest rates would spur some movement. Yet when rates finally started to fall in the third and fourth quarters of 2025, there wasn’t much movement among homeowners. Many chose to stay put.
“In Stamford, interest rates had less impact than people thought,’’ says Penn Johnson, president of Stamford Mortgage. “Yet while many buyers find inventory very limited, it seems to be improving. My pipeline is picking up. We’re seeing accepted offers every week.”
Johnson, with more than 40 years of mortgage experience, was not surprised that the Federal Reserve Board’s rate reduction did not trigger more of a response in mortgage interest rates. “The market sometimes gets ahead of the Fed,’’ he says. “The market expected the Fed would express its intent to continue cutting rates. That’s why mortgage rates didn’t continue to follow through.”
Vikktoria Cooper of Coldwell Banker believes there are additional factors at play that limit the impact of the Fed’s rate reduction.
“First-time homebuyers need a little bit more of a reduction,’’ she says. “They’re unable to get the financing. If we can reach the mid-to-high fives with interest rates, we’ll see some people coming off the fence. On the sellers’ side, their comment is, ‘Where do I go?’ If there is some rate compression, more homeowners might decide to move and take the equity. That would add to the supply. Then we might see a little more movement.”
Johnson said homes that range between $750,000 and $900,000 are Stamford’s sweet spot and attract a lot of interest among potential buyers. “At that price point, it takes some financial strength to be able to afford the home,’’ he says, “especially since many homes are selling for more than their asking price. Rather than finding themselves in repeated multiple offer situations, some buyers decide to look in towns like Trumbull or Stratford. But many people still want to stay in Stamford.”
Many buyers expect rates to continue to decline this year. However, real estate veterans say the return of interest rates in the 3- to 4-percent range, which occurred before and during the pandemic, is likely gone for the foreseeable future.


“Your first property is often your launch pad. You build equity, you learn the process, and you move strategically as your life grows. And most importantly, you don’t have to do it alone. My job is to help young buyers see possibilities, not barriers, and guide them through each step with confidence.”
“I’m expecting to see continued gradual rate improvement in 2026,’’ Johnson says. “If interest rates get a little better, I think inventory will continue to improve. It won’t become a buyer’s market, but it will be a better market. It’s a move forward, and eventually we will return to a more balanced market for buyers and sellers.”
When historians document the first quarter of the 21st century, they will almost certainly use the term “hybrid.” Almost everything, it seems, can be linked with the word, including cars, heating appliances, golf clubs, mattresses and employment. The term is now also applied to real estate. As the city has grown and evolved, some real estate experts now classify Stamford as a hybrid community.
“For me, it means it’s a place that has urban living but also the advantages of suburban living,’’ says Kimberly Tapscott of Keller Williams, a Stamford native who recently concluded a two-year term as the president of the Stamford Board of Realtors. “We look at the area closer to Interstate 95, where you have the train station, theaters, restaurants and the walkability of the city. If you want city living, you can have it downtown. If you want a suburban setting, you can have it in Glenbrook, Springdale or North Stamford.”
In the five years since the pandemic, the most enduring change to Stamford’s real estate landscape is the mushrooming of the hybridity of the city. While it always had urban and suburban appeal, the influx of more rental units and exceedingly tight single-family inventory has helped create a unique situation that has transformed Stamford. More than ever, Stamford has something for everyone, from long-time residents to newcomers who have embraced the city’s cultural complexity and vast amenities.
Remote work has contributed to Stamford’s growth as a hybrid city. “Stamford is uniquely positioned to capitalize on this model on several fronts,’’ says Vikktoria Cooper of Coldwell Banker. “On a micro level, Stamford residents fully appreciate their backyard amenities. They fluidly visit all neighborhoods and form social groups. A renewed sense of community has emerged. On a macro level, Stamford affords its working residents the luxury of being relatively close to their New York offices, increasing their productive time by approximately two hours. Stamford offers a truly unique combination.”
The American Dream has many definitions, but for some people, the prospect of single-family home ownership is still the gold standard. There is, however, a bit of a shift. It has become substantially harder for younger potential buyers to enter the market. Consequently, many people are not buying their first homes until they are well into their 30s.
“In the past, people felt you go to school, get married, buy a house and have a family,’’ says Johnson. “The younger generation is now saying, not so fast. Buying a home is not their only priority. There is more student debt, the home prices are higher, and it takes more of a commitment to get into the market.” Some young buyers are finding a creative workaround, according to Tapscott. Some purchased homes with their parents, a model that allows young people to own a home and enjoy the benefit of childcare.
“There are creative paths to homeownership today that didn’t exist 10 years ago—from down-payment assistance programs and grants to starting with a condo or two-family home as a stepping stone,’’ Tapscott says. “I encourage people to shift the mindset from ‘forever home’ to ‘first home.’ Your first property is often your
launch pad. You build equity, you learn the process, and you move strategically as your life grows. My job is to help young buyers see possibilities, not barriers.”
Many potential young buyers have expressed frustration with their inability to break into the real estate market. Consequently, more rental properties have been established in recent years. Johnson believes the abundance of rental units creates a pool of people looking to buy an entry-level home.
“It is good that there is a growing supply of rental properties, so that employees can move to this area and in some cases, prepare to buy a new home,’’ he says.
“All of the workers who move to our area and start out renting become potential home buyers in the coming years. It’s enabling people to move here to be closer to work and see the benefits of living in the Stamford area. Business growth creates a need for places where employees can live. These are future buyers who will support the housing market.”
There is also a trend among younger residents to seek out rental units or homes that require limited upkeep. But for people who are serious about getting into the market, it’s important to make lifestyle adjustments.
“I tell younger buyers to put themselves on a budget,’’


says Hickey. “Start by cutting all the frivolous things. Drive an older car; don’t trade in the old car because you want a lease. Say no to the overseas trip. If you sacrifice upfront and you’re conscientious, little by little, it adds up so quickly. It takes work, but it can be done.”
It’s always hard to predict how the real estate market will react. Interest rates could fall and usher in a wave of activity. It’s also important to remember that prior to the pandemic, low interest rates and solid inventory helped Stamford maintain a steady flow of transactions.
“When we talk with lenders, they tell us they are getting a lot of applications,’’ Cooper says. “The volume has increased, they have an influx coming in, and they’re getting ready for the spring market. Buyers are getting prepared to run and grab the house they want.”
The National Association of Realtors predicts existing home sales to increase by 14 percent in 2026 and new home sales to increase by 5 percent. The group
expects mortgage rates nationwide to level off around 6 percent and most of all, job gains to increase. The organization also expects strong employment growth, which should benefit the housing industry.
There are no signs that demand to reside in Stamford will abate any time soon. If anything, Stamford’s real estate momentum is surging. Hybrids, as we’ve learned over the past two decades, are hot. People are discovering what Tapscott has known her entire life.
“Stamford was a major beneficiary of the shift after the pandemic,’’ Tapscott says. “Remote and hybrid work opened doors for buyers who once felt tied to New York City. Families began prioritizing space, community and access to nature—qualities Stamford offers in every neighborhood. Even now, five years later, those preferences haven’t faded. During the pandemic, Stamford’s appeal became clearer than ever, and that momentum has not reversed. If anything, it has strengthened Stamford’s identity as a city that offers the ideal balance between urban convenience and suburban comfort.”


Local landscape pros reveal the TRENDS INSPIRING HOMEOWNERS to rethink what’s possible just beyond the back door by tom connor
Backyards across Stamford and Fairfield County are being reimagined—not as leftover green space, but as an essential living space. “Yards matter,” says Heather O’Neill, owner of Second Nature Landscape Design in Norwalk. “People want their property to look beautiful and their houses to be the place to hang out.” As homeowners spend more time outdoors entertaining, relaxing, exercising and even growing their own food, local landscape designers are responding with ideas that blend beauty, function and a sense of escape. We spoke with area professionals who are shaping these outdoor spaces to see what’s defining yard design right now—and what homeowners are asking for this season.
One backyard element that continues to grow in popularity is the in-ground swimming pool.
“During and right after COVID, a lot of real estate agents were asking if there was a pool on the property and, if not, could one be installed,” says Mariana Demoura, co-owner of Oceanview Pool and Patio in Southport. “That feature was particularly important to home buyers moving from the city. If it’s hot out, people want to be in the water at home rather than go to a country club or the beach.”
Local landscape architects agree that a well-designed, resort-style swimming pool elevates a yard’s appeal and perceived value. And certain features are always attractive to owners. They include built-in seating, sunning edges and shelves, shallow ends for children, fountains, hot tubs, vanishing edges that connect water and sky and, for homes with a view of Long Island Sound, outer-edge glass walls.
near the pool include fountains and waterfalls, as the sound of moving water can often calm the senses while simultaneously masking invasive noise from the street.
“It’s not just the sound of splashing in the pool, but something that has a little rhythm. Just as we find peace in music, we find peace in the rhythm of water.”
Nick Ackerman, Glengate
These structural features are in demand today, but the water in the pool is also a powerful design element, with visual and audible virtues. The color in the pool, for instance, immediately draws the eye and soothes the soul. Other popular features
“When remote work became popular, people saw their houses not just as a place to sleep but truly as a place to live,” says Nick Ackerman, a designer at Glengate, the landscape, pool and lifestyle company in Wilton. “Amenities people found while travelling or on vacation started to be created on their own property.”
At the same time, says Ackerman, the company noted “a strong shift away from overly formal, high-maintenance landscapes. More people wanted environments that felt natural and livable.” Today, that’s translated to preferences for organic shapes over linear forms, and natural colors and native plantings around pool areas. These elements can do more than just create an aesthetically pleasing environment.
For a one-acre property close to a busy road and traffic in Ridgefield, Glengate introduced several water features to help drown out some of the distracting sound and create a more calming environment. In addition, a stand-alone spa close to

the house spills into a new swimming pool with a vanishing edge that, in turn, spills into a lower basin. A valving system with multiple levels controls the flow—and sound—of water emptying from the central pool to the basin below the vanishing edge, helping drown out the noise from the street.
“That’s where you’re getting the consistent calming sound of water flowing,” says Ackerman. “It’s not just the sound of splashing in the pool but something that has a little rhythm. Just as we find peace in music, we find peace in the rhythm of water.”
Meanwhile, the stonework that surrounds the pool—and other outdoor areas such as the dining space and firepit—continues to evolve. Plain slabs of rock are giving way to stone masonry threaded with ornamental grasses and gravel. There’s also a wider range of materials in use, from limestone, bluestone and granite to classic coverings like brick pavers, porcelain tiles, stamped concrete and recycled rubber pavers. As a result, today’s patio is more than an extension of a house’s indoor flooring. It’s a singular design element.

One of the most colorful trends in landscaping challenges the notion that you need serious acreage to create eye-catching design. You don’t. What you do need are pots, containers and a talent for packing them to overflowing with as many plants and as much color and contrast as possible.
“A container with flowers and herbs and some kind of shrub softens the whole patio,” says O’Neill. “To have all that texture and color is like a garden within itself, and if you have multiple pots, you get multiple landscapes. And if you don't like what you’ve done? Rip it out and start over.”
O’Neill uses stone or composite containers to hold mixtures of practically anything that grows. She selects plantings that complement the style of the house and the size of the property. It’s also important to scale containers to a space. Small pots, for instance, should not be placed at the entrance to the house, around large dining and seating areas, or against the backdrop of ample acreage, because they are likely to get swallowed up.
Micro-gardens in containers can flourish all season, although some designers will change them out. Regular watering is critical for maintaining them. Most of O’Neill’s clients have sprinkler systems that drip water directly into the pots, so they don’t have to water by hand. One of the benefits of gardening on this miniature scale, says O’Neill, is that it allows for experimentation without a big investment in time and money. And the results can be amazing.
Last December, Sandy Lindh received what she calls an unusual request. “It was for plantings in pots, of vegetables mixed with edible flowers,” says the owner of English Gardens & Design in Greenwich. Soon after, other requests for the same type of containers came in. Some people wanted specific vegetables; mini-tomatoes, eggplants, snow peas and sweet peas were popular requests.
So, Lindh set off on a hunt for large, handsome pots and planters. She found some in a shop outside of Paris and others closer to home, at Pennoyer Newman, an online supplier of high-end garden containers made in Santa Monica, California. The containers are stone resin replicas cast from original planters from
the gardens of great estates here and abroad.
Now, Lindh and other designers are mixing flowering plants, shrubs, herbs and edibles all together in a single container. They position them around outdoor dining and seating areas. In addition, they plant grape vines and runner beans to hang over pergolas, and they grow espalier apples and other fruit vertically up outer walls. “People are asking for this sort of ornamental but veggie all-purpose look,” Lindh says. “We like to feel we're in this beautiful, allencompassing, edible garden room.”
Meanwhile, Homefront Farmers in Redding continues to see demand for the full-size vegetable gardens it designs and installs in raised beds protected by fencing. The company
says clients like the idea of practicing yoga and meditation, or simply enjoying morning coffee, near the flutter of winged things pollinating and gathering nectar in the gardens. But the real appeal is the opportunity to walk out the back door and gather greens for dinner and fresh-cut flowers for the table.
“Instead of having to run to the grocery store, burn gas and waste time sitting in traffic, you can pop out to your garden and pick a delicious, fresh salad for yourself and your family,” says Miranda Gould, director of operations. Customers’ most common requests for this season, says Gould, are heirloom tomatoes, lettuces, cucumbers and peppers, plus dahlias and muted zinnias for the flower beds.




One of the fallouts from the COVID-19 pandemic, at least in parts of Fairfield County, was the temporary closure of public and private country clubs and golf courses. That was a tough time for some residents, as they had to work through the mood swings associated with putting-green withdrawal. But as a result, the demand for at-home artificial putting greens increased. And it continues to do so.
“Along with the pool guys, we were busy during COVID,” says Neil Robertson, founder of Prolinks Putting Greens in Wilton. The company has been designing and installing custom home putting greens since the early 1990s. “Recently, there’s been an uptick in business, and our projects have gotten more elaborate, with more bells and whistles and multiple traps. We’re also getting requests to use the same sand as clients have at their clubs.”
Prolinks uses artificial nylon grass on its greens and synthetic fringe collars around the edges. For the traps or bunkers, it relies on a third-generation company that supplies a custom mix of natural sand to all the golf courses in Fairfield and Westchester counties. The main benefits of artificial turf on a putting green include year-round consistency of a smooth, predictable surface and low maintenance. You don’t have to water, fertilize or mow it. “All putting, no cutting,” says Robertson.
For Robertson, the process of building the green starts with walking the property with a client. He’ll take note of preferences, the lay of the land (including elevations), green size relative to the size of the house and ideal positions for the traps. Robertson then paints an outline of the green on the location. After removing all the organic material from the
footprint, he installs a compacted aggregate base of reclaimed material—crushed rocks, asphalt and brick—until reaching the desired contours.
“The quality of artificial turf mimics a real putting green as far as the roll and speed of the ball,” he says. “So it's comparable to a good country club.”
Taken together, these trends point to a simple idea: Today’s landscapes are designed to be lived in. Whether it’s a pool that turns a backyard into a summer destination, a container garden that brings color and fresh food within arm’s reach, or a putting green that keeps a favorite pastime close to home, residents are investing in outdoor spaces that reflect how they spend their time. It’s proof that some of the most meaningful improvements to a home don’t always happen indoors.

Local interior designers share what they’re seeing in homes this spring , and what a lot of clients seem to be feeling by kim kavin

After years of cool grays and blues being on point, local interior designers say the pendulum is swinging —in part because that’s how pendulums work, and in part because the state of the world has people stressed and seeking comfort.
“I put music to everything, and my soundtrack right now is Have You Ever Seen the Rain by Credence Clearwater Revival,” says Karen Bow of Karen Bow Interiors in Darien. “I think that epitomizes what is going on in the world and what’s happening with my clients. People hire me to bring the calm. There’s an emotional level to it right now. People are looking to maximize what they have. They’re not looking to make big changes. We’re all a little weary. All we’re looking for is the possibility of change. And maybe it’s as simple as a throw pillow.”
Whether it’s making small or big adjustments, freshening up classic pieces or reconfiguring rooms to make them more usable, clients are asking interior designers for help with making home feel more homey this spring.
Michelle Morgan of Morgan Harrison Home in New Canaan is one of several leading designers who say people are craving warmer tones all around them.
“We have been in cool colors for over a decade. Really, 15 years or so,” she says. “And the eye is done with the cold. We’re warming again. The palettes are reverting back from blues that are now warmer greens. It’s not a purply-gray blue. It’s warmer. The grays are turning to graybeiges. Even dark woods again, dark walnut.”
Douglas Graneto of Douglas Graneto Design in Westport and Darien is another designer receiving requests for more soothing shades.
“I have seen a really big move toward warmer tones,” he says. “People are warming up their houses and moving toward creams and green tones.”
Graneto adds that for some people, it’s simply that things go in cycles, and these shades can feel fresh and new right now. “We’ve embraced gray for quite some time, and when we fully dove into the cooler tones, that felt fresh because in the eighties and nineties, everything had a yellow and brown undertone to it,” he says. “That’s why the blues and grays felt crisp and new and exciting. It’s not that it’s done—blues and gray tones will always have a place in design—but the warmer tones feel softer and new again.”
Christina Roughan is seeing much the same thing at her firm, Roughan Interiors in Weston, but with some clients specifically looking to color drenching to achieve the desired effect.
“I think it started in the fall, really, the warm neutrals and earth tones—beiges, terra cotta, rust,” she says. “Everyone is going in a way that’s just more homey and inviting. Even in contemporary homes, which we do too, it’s color drenching, and that doesn’t have to be a dark color. It can be a beautiful green, like a moss green.”
Color drenching is the idea of having everything in a room—from the ceiling to the accessories—done in the same color, or in variations on the same color. Bow says she’s also seeing clients lean into the idea.
“Color in abundance becomes a neutral,” Bow says. “It’s as serene as serene can be. It happens by layering combinations of color in abundance. You don’t accent something unless you want it accented. Trim is out. If you do the walls gray and the trim white, you’re accenting trim. Why? If you have beautiful molding and you want to bring attention to that, do it, but in a kitchen, maybe the cabinets are one shade of green, the walls are another shade of green, maybe there are four or five shades of green, and that makes the color become neutral.”

“Everyone is going in a way that’s just more homey and inviting.”
CHRISTINA ROUGHAN, Roughan Interiors




“Add some wood frames or ceramic frames that have a warmer feel.”
DOUGLAS GRANETO, Douglas Graneto Design

Roughan says clients don’t have to make huge changes to feel a real difference.
“Just having different artwork in a space drastically changes the look and the feel,” she says. “You could have a caramel suede throw pillow on an ivory sofa to make it more inviting. Maybe heavy fringe. That can add a lot of depth and softness. Or what I love to do is search the globe for decorative smalls that really make an environment, like a beautiful bowl from the South of France that nobody else has, and you put it on your coffee table. Things like that—they really have provenance, and when you walk into a room and sit down, that could be a conversation. You talk about travel or the arts. There’s a lot that goes into every single light fixture. Individual things can be very special.”
Bow says a similar result can be achieved by introducing a new texture to a room. “I have a client with a lot of antiques. You can’t add another antique or another wood, but you want to freshen it up. So you add metals,” Bow says. “You could do the obvious brass or nickel, but I try to do textured or colored metals.”
Graneto says that even changing out some of the smallest accessories can brighten up a room. “Maybe it’s not all silver picture frames,” he says. “Add some wood or ceramic frames that have a warmer feel.”
Reupholstering can take things up a notch in a similar way, he adds. “If you have sofas or chairs that you love, reupholstering them is a way to use what you love and make them feel fresh again. If you have an antique chair from grandma, and it’s a shape that you like, reupholstering brings new life to it.”
Roughan says that simply switching up what’s in a room can make a big difference as well. “Move things around. Move things out,” she says. “It’s like a refresh, and it gives you more mojo to do the next step. You sit back and think, this looks great.”
Bow also says that reconfiguring a space can give it a major boost. “People are looking at their traditional rooms and thinking they love it, but they’re not really using it very much. So, they’re turning these areas into dual-purpose rooms,” she says. “I have a couple of formal living rooms where we’ve incorporated game tables to transform the spaces into entertaining rooms. Or maybe we do an air hockey table, but it has a custom top on it, so it’s styled as a library table.” The addition of a custom Steinway piano is another option.”
All these ideas, she adds, are ultimately about feeling even more at home, when you’re at home. “I think it really is about maximizing what you have,” Bow says. “Love the home you’re with.”








Spring has officially sprung at the Stamford Museum & Nature Center, where blooms, birdsong and barnyard personalities come alive. Among the season’s most endearing sights is Petunia, a 22-year-old Scottish Highland cow and longtime resident of the Nature Center’s Heckscher Farm. With her double coat, sweeping horns and fluttery eyelashes, Petunia embodies the timeless appeal of one of the world’s oldest heritage cattle breeds. Known for their gentle temperament and hardy spirit, Highland cows feel right at home in this pastoral setting. As the landscape greens, there’s no better time to wander the grounds and say hello to the season’s shaggiest ambassador.










